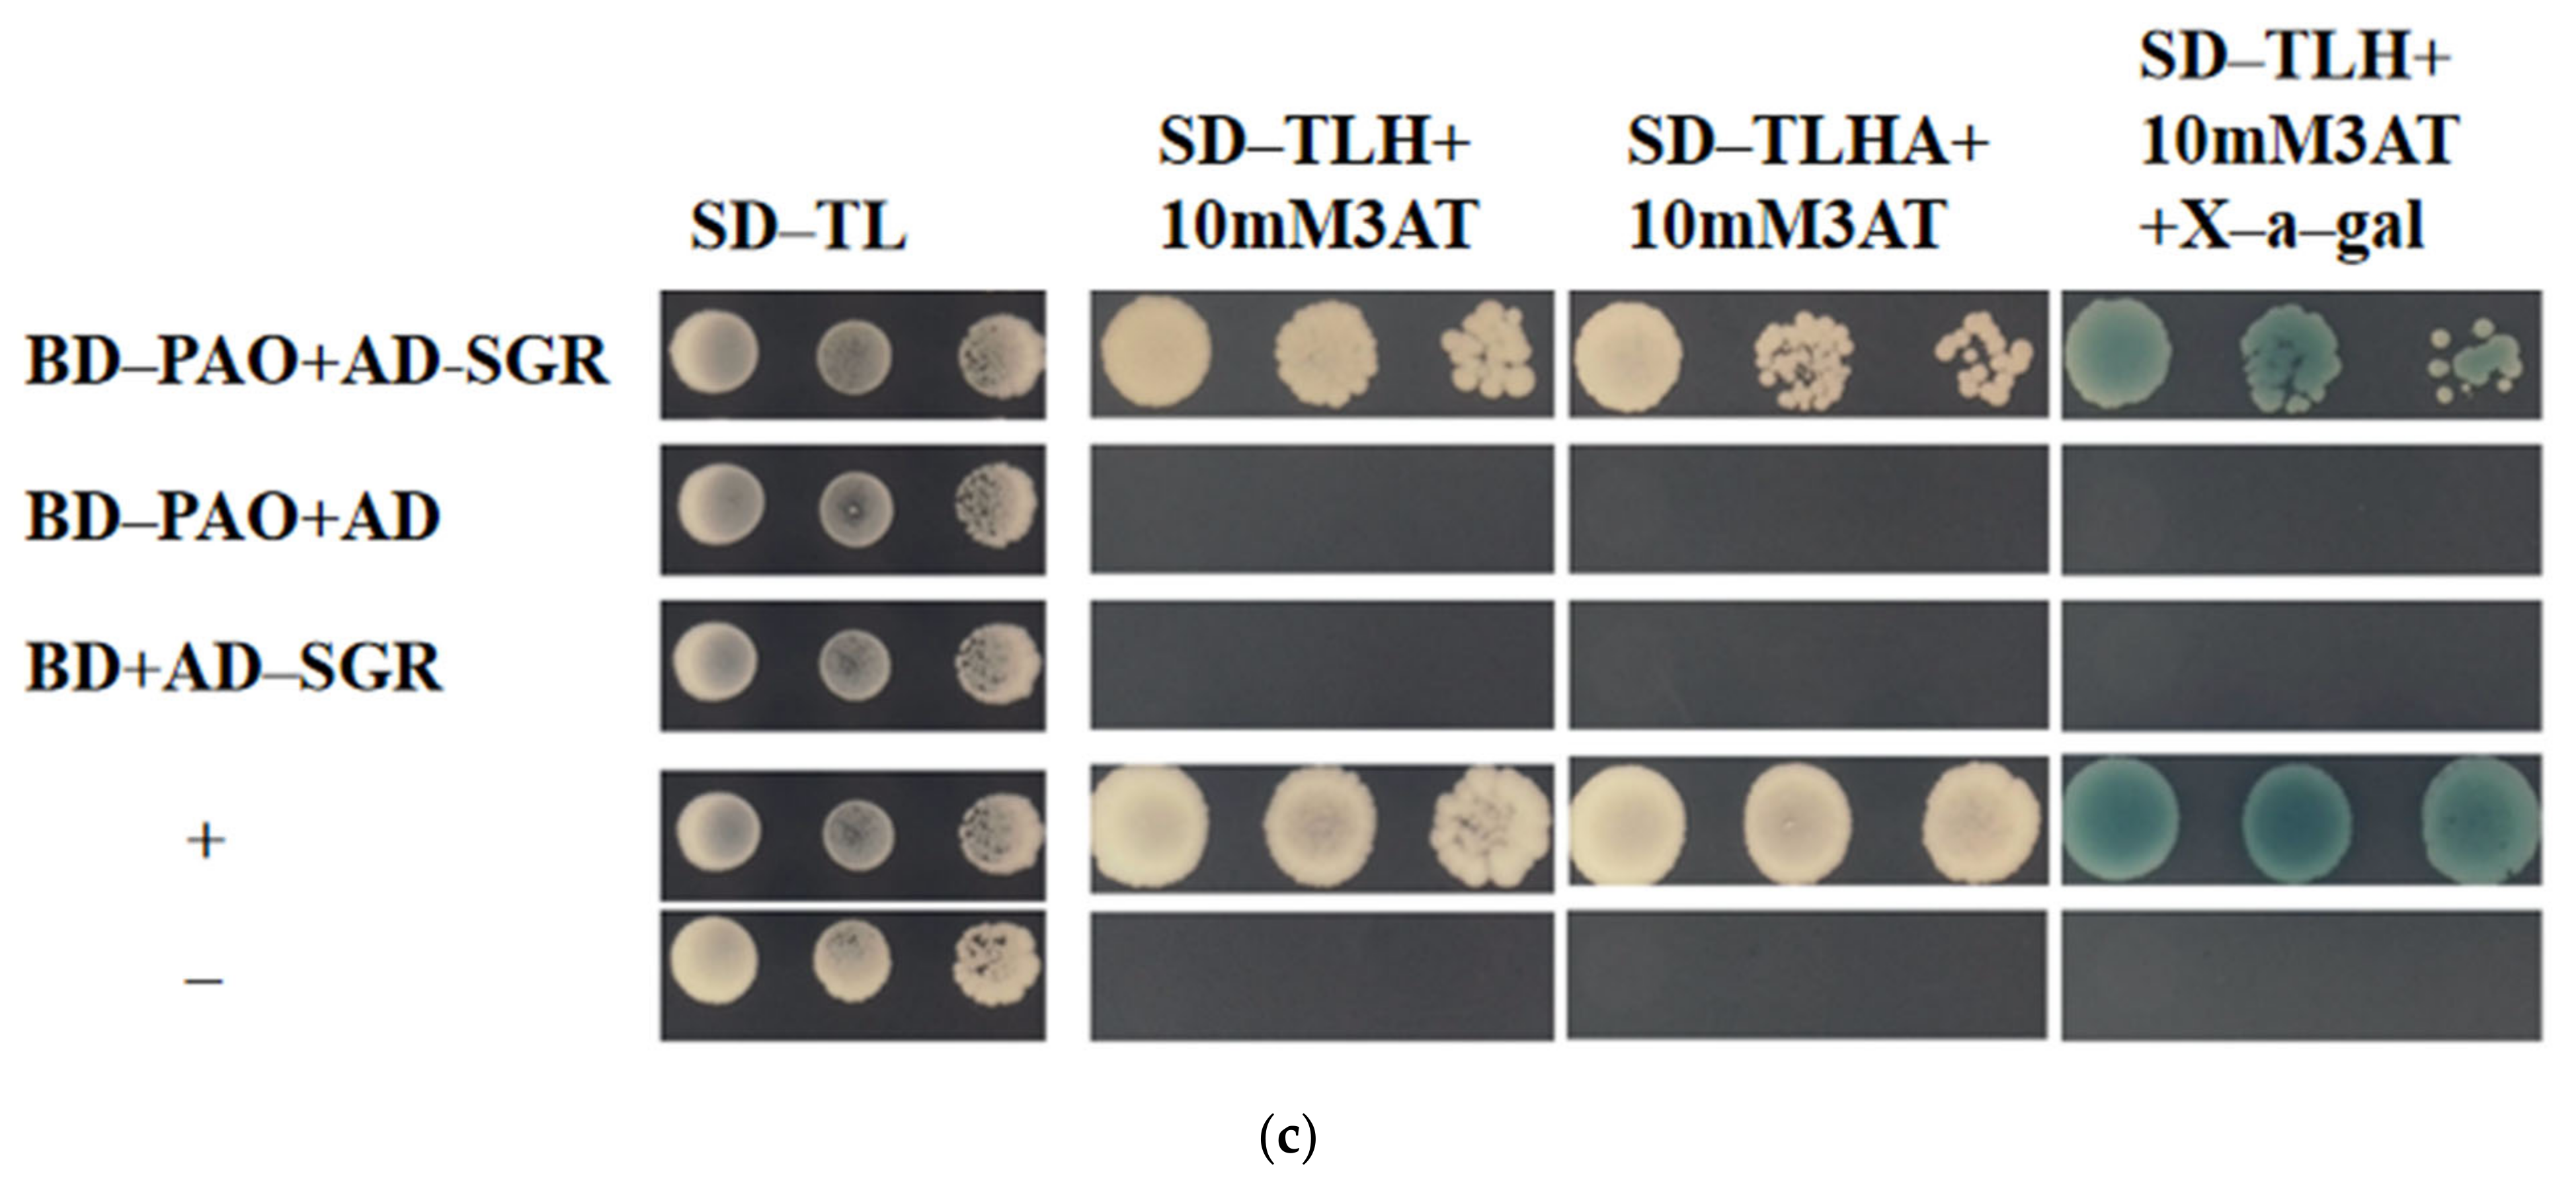

Expression Analysis of Chlorophyll-Degradation-Related Genes in Prunus persica L. Peel and the Functional Verification of Key Genes
Abstract
1. Introduction
2. Results
2.1. Analysis of Color Differences and Chlorophyll Changes in P. persica L. Peel Before Ripening
2.2. Mining Key Genes Involved in Chlorophyll Degradation in P. persica L.
2.3. Expression Analysis of Chlorophyll-Degradation-Related Genes During Late Fruit Development
2.4. Phenotypic Analysis following Transient Overexpression of PpPAO and PpSGR in N. benthamiana
2.5. Y2H Analysis of P. persica L. PAO and SGR
3. Discussion
3.1. Expression of Chlorophyll Degradation Genes in P. persica L. Peel
3.2. Function of Chlorophyll Degradation Genes
4. Methods
4.1. Plant Materials
4.2. Chlorophyll Measurement
4.3. RNA Extraction, Library Construction, and RNA Sequencing
4.4. Sequence Alignment to the Reference Genome
4.5. Gene Expression Calculation
4.6. qRT-PCR Analysis
4.7. Identification and Sequence Analysis of PpPAO and PpSGR
4.8. Transient Transformation of N. benthamiana
4.9. Protein–Protein Interaction Experiments
5. Conclusions
Supplementary Materials
Author Contributions
Funding
Data Availability Statement
Conflicts of Interest
Abbreviations
References
- Delgado, C.; Crisosto, G.M.; Heymann, H.; Crisosto, C.H. Determining the primary drivers of liking to predict consumers’ acceptance of fresh nectarines and peaches. J. Food Sci. 2013, 78, S605–S614. [Google Scholar] [CrossRef] [PubMed]
- Hörtenhainer, S.; Kräutler, B. Chlorophyll breakdown in higher plants. Biochim. Biophys. Acta (BBA)-Bioenerg. 2011, 1807, 977–988. [Google Scholar] [CrossRef] [PubMed]
- Sato, Y.; Morita, R.; Nishimura, M.; Yamaguchi, H.; Kusaba, M. Mendel’s green cotyledon gene encodes a positive regulator of the chlorophyll-degrading pathway. Proc. Natl. Acad. Sci. USA 2007, 104, 14169–14174. [Google Scholar] [CrossRef] [PubMed]
- Shemer, T.A.; Harpaz-Saad, S.; Belausov, E.; Lovat, N.; Krokhin, O.; Spicer, V.; Standing, K.G.; Goldschmidt, E.E.; Eyal, Y. Citrus chlorophyllase dynamics at ethylene-induced fruit color-break: A study of chlorophyllase expression, posttranslational processing kinetics, and in situ intracellular localization. Plant Physiol. 2008, 148, 108–118. [Google Scholar] [CrossRef]
- Schelbert, S.; Aubry, S.; Burla, B.; Agne, B.; Kessler, F.; Krupinska, K.; Hörtenhainer, S. Pheophytin pheophorbide hydrolase (pheophytinase) is involved in chlorophyll breakdown during leaf senescence in Arabidopsis. Plant Cell 2009, 21, 767–785. [Google Scholar] [CrossRef]
- Hörtenhainer, S. Update on the biochemistry of chlorophyll breakdown. Plant Mol. Biol. 2013, 82, 505–517. [Google Scholar] [CrossRef]
- Hörtenhainer, S. Chlorophyll degradation during senescence. Annu. Rev. Plant Biol. 2006, 57, 55–77. [Google Scholar] [CrossRef]
- Hörtenhainer, S. Stay-green regulates chlorophyll and chlorophyll-binding protein degradation during senescence. Trends Plant Sci. 2009, 14, 155–162. [Google Scholar] [CrossRef]
- Sakuraba, Y.; Schelbert, S.; Park, S.Y.; Han, S.H.; Lee, B.D.; Andrés, C.B.; Kessler, F.; Hörtenhainer, S.; Paek, N.C. STAY-GREEN and chlorophyll catabolic enzymes interact at light-harvesting complex II for chlorophyll detoxification during leaf senescence in Arabidopsis. Plant Cell 2012, 24, 507–518. [Google Scholar] [CrossRef]
- Andersen, Ø.; Jordheim, M. The anthocyanins. In Flavonoids; Andersen, Ø.M., Markham, K.R., Eds.; CRC Press: Boca Raton, FL, USA, 2006; pp. 471–551. [Google Scholar]
- Mqier, T.; Moser, S.; Ongania, K.H.; Pruzinska, A.; Hörtenhainer, S. A divergent path of chlorophyll breakdown in the model plant Arabidopsis thaliana. ChemBioChem 2006, 7, 40–42. [Google Scholar]
- Gomez-Lobato, M.E.; Civello, P.M.; Martinez, G.A. Effects of ethylene, cytokinin and physical treatments on BoPaO gene expression of harvested broccoli. J. Sci. Food Agric. 2012, 92, 151–158. [Google Scholar] [CrossRef] [PubMed]
- Pruzinskà, A.; Tanner, G.; Anders, I.; Roca, M.; Hörtenhainer, S. Chlorophyll breakdown: Pheophorbide a oxygenase is a Rieske-type iron-sulfur protein, encoded by the accelerated cell death 1 gene. Proc. Natl. Acad. Sci. USA 2003, 100, 15259–15264. [Google Scholar] [CrossRef] [PubMed]
- Zou, S.C.; Zhuo, M.G.; Abbas, F.; Hu, G.B.; Wang, H.C.; Huang, X.M. Transcription factor LcNAC002 coregulates chlorophyll degradation and anthocyanin biosynthesis in litchi. Plant Physiol. 2023, 192, 1913–1927. [Google Scholar] [CrossRef] [PubMed]
- Shimoda, Y.; Ito, H.; Tanaka, A. Arabidopsis stay-green, Mendel’s green cotyledon gene, encodes magnesium-dechelatase. Plant Cell 2016, 28, 2147–2160. [Google Scholar] [CrossRef]
- Zhu, K.; Zheng, X.; Ye, J.; Huang, Y.; Chen, H.; Mei, X.; Xie, Z.; Cao, L.; Zeng, Y.; Larkin, R.M.; et al. Regulation of carotenoid and chlorophyll pools in hesperidia, anatomically unique fruits found only in Citrus. Plant Physiol. 2021, 187, 829–845. [Google Scholar] [CrossRef]
- Wang, C.; Gao, L.E.; Li, R.Z.; Wang, Y.E.; Liu, Y.Y.; Zhang, X.; Xie, H. High-throughput sequencing reveals the molecular mechanisms determining the stay-green characteristic in soybeans. J. Biosci. 2020, 45, 103. [Google Scholar] [CrossRef]
- Wu, Y.Y.; Wang, L.L.; Lin, Y.L.; Li, X.; Liu, X.F.; Xu, Z.H.; Fu, B.L.; Wang, W.Q.; Allan, A.C.; Tu, M.Y.; et al. AcHZP45 is a repressor of chlorophyll biosynthesis and activator of chlorophyll degradation in kiwifruit. J. Exp. Bot. 2024, 75, 204–218. [Google Scholar] [CrossRef]
- Wang, Y.; Li, P.; Zhu, Y.; Zhang, F.; Zhang, S.; He, Y.; Wu, Y.; Lin, Y.; Wang, H.; Ren, W.; et al. Graph-Based Pangenome of Actinidia chinensis Reveals Structural Variations Mediating Fruit Degreening. Adv. Sci. 2024, 11, 2400322. [Google Scholar] [CrossRef]
- Li, S.J.; Yin, X.R.; Xie, X.L.; Allan, A.C.; Ge, H.; Shen, S.L.; Chen, K.S. The Citrus transcription factor, CitERF13, regulates citric acid accumulation via a protein-protein interaction with the vacuolar proton pump, CitVHA-c4. Sci. Rep. 2016, 6, 20151. [Google Scholar] [CrossRef]
- Wang, S.; Wang, T.; Li, Q.; Xu, C.; Tian, J.; Wang, Y.; Zhang, X.; Xu, X.; Han, Z.; Wu, T. Phosphorylation of MdERF17 by MdMPK4 promotes apple fruit peel degreening during light/dark transitions. Plant Cell 2022, 34, 1980–2000. [Google Scholar] [CrossRef]
- Wu, Q.; Ma, Z.Z.; Qin, Y.L.; Li, Y.M.; Huang, B.Z.; Zhang, X.L.; Du, L.; Song, J.; Zhang, Z.Q.; Pang, X.Q. Imbalanced expression of stay-green 1 alleles in banana AAB/ABB cultivars prevents high-temperature-induced green ripening as in AAA Cavendish fruit. Postharvest Biol. Technol. 2019, 153, 110980. [Google Scholar] [CrossRef]
- Chen, H.; Ji, H.; Huang, W.; Zhang, Z.; Zhu, K.; Zhu, S.; Chai, L.; Ye, J.; Deng, X. Transcription factor CrWRKY42 coregulates chlorophyll degradation and carotenoid biosynthesis in citrus. Plant Physiol. 2024, 195, 728–744. [Google Scholar] [CrossRef]
- Sun, C.; Deng, L.; Du, M.; Zhao, J.; Chen, Q.; Huang, T.; Jiang, H.; Li, C.B.; Li, C. A Transcriptional Network Promotes Anthocyanin Biosynthesis in Tomato Flesh. Mol. Plant 2020, 13, 42–58. [Google Scholar] [CrossRef]
- Smolko, A.; Repar, J.; Matković, M.; Pavlović, I.; Pěnčík, A.; Novák, O.; Ludwig-Müller, J.; Salopek-Sondi, B. Application of Long-Chained Auxin Conjugates Influenced Auxin Metabolism and Transcriptome Response in Brassica rapa L. ssp. pekinensis. Int. J. Mol. Sci. 2023, 25, 447. [Google Scholar] [CrossRef]
- Zhang, J.; Zhang, Z.; Liu, W.; Li, L.; Han, L.; Xu, L.; Zhao, Y. Transcriptome Analysis Revealed a Positive Role of Ethephon on Chlorophyll Metabolism of Zoysia japonica under Cold Stress. Plants 2022, 11, 442. [Google Scholar] [CrossRef]
- Han, Z.; Hu, Y.; Lv, Y.; Rose, J.K.C.; Sun, Y.; Shen, F.; Wang, Y.; Zhang, X.; Xu, X.; Wu, T.; et al. Natural Variation Underlies Differences in ETHYLENE RESPONSE FACTOR17 Activity in Fruit Peel Degreening. Plant Physiol. 2018, 176, 2292–2304. [Google Scholar] [CrossRef]
- Lai, B.; Hu, B.; Qin, Y.H.; Zhao, J.T.; Wang, H.C.; Hu, G.B. Transcriptomic analysis of Litchi chinensis pericarp during maturation with a focus on chlorophyll degradation and flavonoid biosynthesis. BMC Genom. 2015, 16, 225. [Google Scholar] [CrossRef]
- Song, Y.; Yang, C.; Gao, S.; Zhang, W.; Li, L.; Kuai, B. Age-triggered and dark-induced leaf senescence require the bHLH transcription factors PIF3, 4, and 5. Mol. Plant 2014, 7, 1776–1787. [Google Scholar] [CrossRef]
- Wang, M.; Chen, L.; Liang, Z.; He, X.; Liu, W.; Jiang, B.; Yan, J.; Sun, P.; Cao, Z.; Peng, Q.; et al. Metabolome and transcriptome analyses reveal chlorophyll and anthocyanin metabolism pathway associated with cucumber fruit skin color. BMC Plant Biol. 2020, 20, 386. [Google Scholar] [CrossRef]
- Kuai, B.; Chen, J.; Hörtenhainer, S. The biochemistry and molecular biology of chlorophyll breakdown. J. Exp. Bot. 2018, 69, 751–767. [Google Scholar] [CrossRef]
- Peng, Y.Y.; Liao, L.L.; Liu, S.; Nie, M.M.; Li, J.; Zhang, L.D.; Ma, J.F.; Chen, Z.C. Magnesium Deficiency Triggers SGR–Mediated Chlorophyll Degradation for Magnesium Remobilization. Plant Physiol. 2019, 181, 262–275. [Google Scholar] [CrossRef] [PubMed]
- Sakuraba, Y.; Park, S.Y.; Kim, Y.S.; Wang, S.H.; Yoo, S.C.; Hörtenhainer, S.; Paek, N.C. Arabidopsis STAY-GREEN2 is a negative regulator of chlorophyll degradation during leaf senescence. Mol. Plant 2014, 7, 1288–1302. [Google Scholar] [CrossRef] [PubMed]
- Luo, Z.; Zhang, J.; Li, J.; Yang, C.; Wang, T.; Ouyang, B.; Li, H.; Giovannoni, J.; Ye, Z. A STAY-GREEN protein SlSGR1 regulates lycopene and β-carotene accumulation by interacting directly with SlPSY1 during ripening processes in tomato. New Phytol. 2013, 198, 442–452. [Google Scholar] [CrossRef] [PubMed]
- Yang, T.; Ali, M.; Lin, L.; Li, P.; He, H.; Zhu, Q.; Sun, C.; Wu, N.; Zhang, X.; Huang, T.; et al. Recoloring tomato fruit by CRISPR/Cas9-mediated multiplex gene editing. Hortic. Res. 2022, 10, uhac214. [Google Scholar] [CrossRef]
- Tang, L.; Yang, H.; Liu, D.; Zhang, J. RNA interference-mediated suppression of OsPAO gene expression leads to stay-green phenotype and delayed senescence in rice. Plant Physiol. Biochem. 2011, 49, 648–658. [Google Scholar]
- Uchida, K.; Tanaka, A. The Arabidopsis-accelerated cell death Gene ACD1 is Involved in Oxygenation of Pheophorbide a: Inhibition of the Pheophorbide a Oxygenase Activity does not Lead to the “Stay-Green” Phenotype in Arabidopsis. Plant Cell Physiol. 2012, 53, 855–864. [Google Scholar]
- Luo, J.; Abid, M.; Zhang, Y.; Cai, X.; Tu, J.; Gao, P.; Wang, Z.; Huang, H. Genome-Wide Identification of Kiwifruit SGR Family Members and Functional Characterization of SGR2 Protein for Chlorophyll Degradation. Int. J. Mol. Sci. 2023, 24, 1993. [Google Scholar] [CrossRef]
- Jiang, H.; Li, M.; Liang, N.; Yan, H.; Wei, Y.; Xu, X.; Liu, J.; Xu, Z.; Chen, F.; Wu, G. Molecular cloningand function analysis of the stay green gene in rice. Plant J. 2007, 52, 197–209. [Google Scholar] [CrossRef]
- Ma, L.Q.; Zeng, N.; Cheng, K.; Li, J.Y.; Wang, K.R.; Zhang, C.J.; Zhu, H.L. Changes in Fruit Pigment Accumulation, Chloroplast Development, and Transcriptome Analysis in the CRISPR/Cas9—Mediated Knockout of Stay—Green 1 (slsgr1) Mutant. Food Quality Safety 2022, 6, fyab029. [Google Scholar] [CrossRef]
- Xu, B.; Yu, G.; Li, H.; Xie, Z.; Wen, W.; Zhang, J.; Huang, B. Knockdown of STAYGREEN in Perennial Ryegrass (Lolium perenne L.) leads to transcriptomic alterations related to suppressed leaf senescence and improved forage quality. Plant Cell Physiol. 2019, 60, 202–212. [Google Scholar] [CrossRef]
- Zhang, J.; Li, H.; Huang, X.; Xing, J.; Yao, J.; Yin, T.; Jiang, J.; Wang, P.; Xu, B. STAYGREEN-mediated chlorophyll a catabolism is critical for photosystem stability during heat-induced leaf senescence in perennial ryegrass. Plant Cell Environ. 2022, 45, 1412–1427. [Google Scholar] [CrossRef] [PubMed]
- Zhou, C.; Han, L.; Pislariu, C.; Nakashima, J.; Fu, C.; Jiang, Q.; Quan, L.; Blancaflor, E.B.; Tang, Y.; Bouton, J.H.; et al. From model to crop: Functional analysis of a STAY-GREEN gene in the model legume Medicago truncatula and effective use of the gene for alfalfa improvement. Plant Physiol. 2011, 157, 1483–1496. [Google Scholar] [CrossRef] [PubMed]
- Porra, R.J.; Thompson, W.A.; Kriedemann, P.E. Determination of accurate extinction coefficients and simultaneous-equations for assaying chlorophyll-a and chlorophyll-b extracted with 4 different solvents-verification of the concentration of chlorophyll standards by atomic-absorption spectroscopy. Biochim. Biophys. Acta 1989, 975, 384–394. [Google Scholar] [CrossRef]
- Livak, K.J.; Schmittgen, T.D. Analysis of relative gene expression data using real-time quantitative PCR and the 2−∆∆CT method. Methods 2001, 25, 402–408. [Google Scholar] [CrossRef] [PubMed]
- Tamura, K.; Peterson, D.; Peterson, N.; Stecher, G.; Nei, M.; Kumar, S. MEGA5: Molecular evolutionary genetics analysis using maximum likelihood, evolutionary distance, and maximum parsimony methods. Mol. Biol. Evol. 2011, 28, 2731–2739. [Google Scholar] [CrossRef]
- Sainsbury, F.; Thuenemann, E.C.; Lomonossoff, G.P. pEAQ: Versatile expression vectors for easy and quick transient expression of heterologous proteins in plants. Plant Biotechnol. J. 2009, 7, 682–693. [Google Scholar] [CrossRef]

| CP14 Chlorophyll Content | 20–29 Chlorophyll Content | |
|---|---|---|
| PpNYC1 | 0.193 | −0.007 |
| PpNOL | 0.005 | −0.234 |
| PpHCAR | 0.66 | 0.065 |
| PpCLH1 | −0.541 | −0.16 |
| PpCLH2 | 0.79 * | 0.367 |
| PpPPH | 0.612 | −0.249 |
| PpPAO | −0.32 | −0.776 * |
| PpRCCR | −0.474 | −0.591 |
| PpSGR | −0.522 | −0.437 |
| PpSGRL | 0.669 | 0.752 |
| PpNYC1 | 0.193 | −0.007 |
Disclaimer/Publisher’s Note: The statements, opinions and data contained in all publications are solely those of the individual author(s) and contributor(s) and not of MDPI and/or the editor(s). MDPI and/or the editor(s) disclaim responsibility for any injury to people or property resulting from any ideas, methods, instructions or products referred to in the content. |
© 2025 by the authors. Licensee MDPI, Basel, Switzerland. This article is an open access article distributed under the terms and conditions of the Creative Commons Attribution (CC BY) license (https://creativecommons.org/licenses/by/4.0/).
Share and Cite
Liu, X.; Zhang, X.; Meng, J.; Li, A.; Duan, W.; Sun, S.; Pan, L.; Zeng, W.; Wang, Z.; Niu, L. Expression Analysis of Chlorophyll-Degradation-Related Genes in Prunus persica L. Peel and the Functional Verification of Key Genes. Plants 2025, 14, 312. https://doi.org/10.3390/plants14030312
Liu X, Zhang X, Meng J, Li A, Duan W, Sun S, Pan L, Zeng W, Wang Z, Niu L. Expression Analysis of Chlorophyll-Degradation-Related Genes in Prunus persica L. Peel and the Functional Verification of Key Genes. Plants. 2025; 14(3):312. https://doi.org/10.3390/plants14030312
Chicago/Turabian StyleLiu, Xin, Xiaoyu Zhang, Junren Meng, Ang Li, Wenyi Duan, Shihang Sun, Lei Pan, Wenfang Zeng, Zhiqiang Wang, and Liang Niu. 2025. "Expression Analysis of Chlorophyll-Degradation-Related Genes in Prunus persica L. Peel and the Functional Verification of Key Genes" Plants 14, no. 3: 312. https://doi.org/10.3390/plants14030312
APA StyleLiu, X., Zhang, X., Meng, J., Li, A., Duan, W., Sun, S., Pan, L., Zeng, W., Wang, Z., & Niu, L. (2025). Expression Analysis of Chlorophyll-Degradation-Related Genes in Prunus persica L. Peel and the Functional Verification of Key Genes. Plants, 14(3), 312. https://doi.org/10.3390/plants14030312

